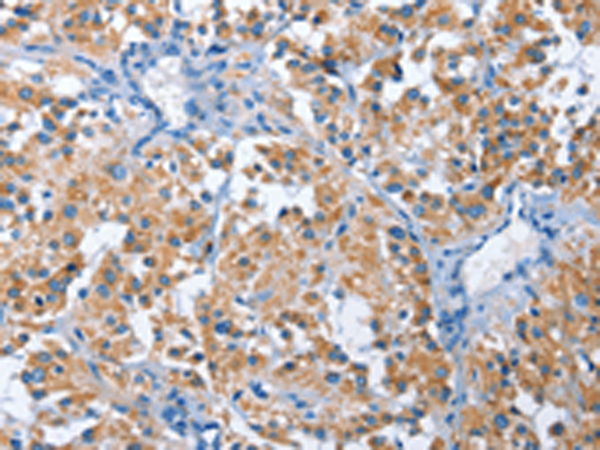
一抗

中文名稱: 兔抗PAK6多克隆抗體
英文名稱: Anti-PAK6 rabbit polyclonal antibody
別 名: PAK5
抗 原: PAK6
儲 存: 冷凍(-20℃)
宿 主: Rabbit
相關(guān)類別: 一抗
反應(yīng)種屬: Human, Mouse
標(biāo) 記 物: Unconjugate
克隆類型: rabbit polyclonal
技術(shù)規(guī)格
|
Background: |
This gene encodes a member of a family of p21-stimulated serine/threonine protein kinases, which contain an amino-terminal Cdc42/Rac interactive binding (CRIB) domain and a carboxyl-terminal kinase domain. These kinases function in a number of cellular processes, including cytoskeleton rearrangement, apoptosis, and the mitogen-activated protein (MAP) kinase signaling pathway. The protein encoded by this gene interacts with androgen receptor (AR) and translocates to the nucleus, where it is involved in transcriptional regulation. Changes in expression of this gene have been linked to prostate cancer. Alternative splicing results in multiple transcript variants. |
|
Applications: |
ELISA, IHC |
|
Name of antibody: |
PAK6 |
|
Immunogen: |
Fusion protein of human PAK6 |
|
Full name: |
p21 protein (Cdc42/Rac)-activated kinase 6 |
|
Synonyms: |
PAK5 |
|
SwissProt: |
Q9NQU5 |
|
ELISA Recommended dilution: |
2000-5000 |
|
IHC positive control: |
Human thyroid cancer |
|
IHC Recommend dilution: |
25-100 |

 購物車
購物車 幫助
幫助
 021-54845833/15800441009
021-54845833/15800441009